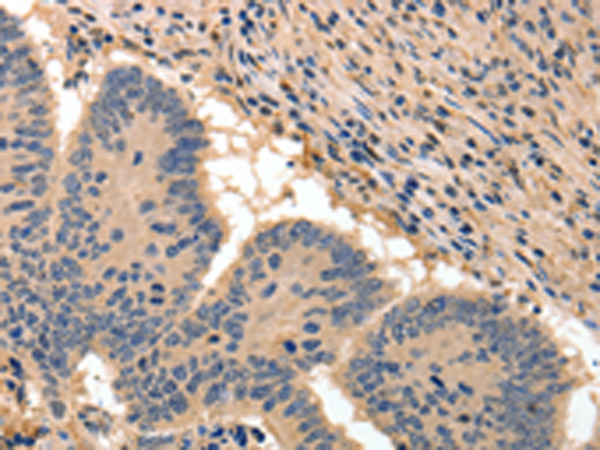

中文名稱:兔抗BAIAP2多克隆抗體
|
Background: |
The protein encoded by this gene has been identified as a brain-specific angiogenesis inhibitor (BAI1)-binding protein. This adaptor protein links membrane bound G-proteins to cytoplasmic effector proteins. This protein functions as an insulin receptor tyrosine kinase substrate and suggests a role for insulin in the central nervous system. It also associates with a downstream effector of Rho small G proteins, which is associated with the formation of stress fibers and cytokinesis. This protein is involved in lamellipodia and filopodia formation in motile cells and may affect neuronal growth-cone guidance. This protein has also been identified as interacting with the dentatorubral-pallidoluysian atrophy gene, which is associated with an autosomal dominant neurodegenerative disease. Alternative splicing results in multiple transcript variants encoding distinct isoforms |
|
Applications: |
ELISA, IHC |
|
Name of antibody: |
BAIAP2 |
|
Immunogen: |
Fusion protein of human BAIAP2 |
|
Full name: |
BAI1-associated protein 2 |
|
Synonyms: |
BAP2, FLAF3, IRSP53 |
|
SwissProt: |
Q9UQB8 |
|
ELISA Recommended dilution: |
2000-5000 |
|
IHC positive control: |
Human colon cancer |
|
IHC Recommend dilution: |
50-200 |
購物車
購物車 幫助
幫助
 021-54845833/15800441009
021-54845833/15800441009
